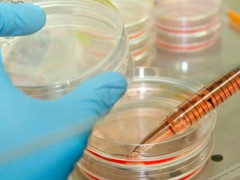

В Благовещенске построят спорткомплекс для боевых искусств
В Благовещенске отпраздновали 80-летие со дня признания самбо как вида спорта в России. На торжественном концерте с показательными выступлениями глава Приамурья Василий Орлов поздравил спортсменов с юбилейной датой. Губернатор сообщил, что в Благовещенске будет построен физкультурно-оздоровительный комплекс для боевых искусств.